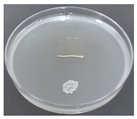
Pharmaceutics 14 01302 i002
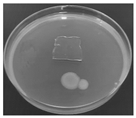
Pharmaceutics 14 01302 i004
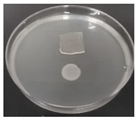
Pharmaceutics 14 01302 i005
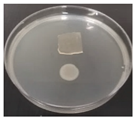
Pharmaceutics 14 01302 i006

Formulation and Optimal Design of Dioscorea bulbifera and Honey-Loaded Gantrez®/Xyloglucan Hydrogel as Wound Healing Patches
Abstract
:1. Introduction
2. Materials and Methods
2.1. Materials
2.2. Preparation of D. bulbifera Extract
2.3. Formulation of the Hydrogel Patches
2.4. Optimization of the Hydrogel Patches by Experimental Design
2.5. Embedding of D. bulbifera Extract to Optimized Film
2.6. Fourier-Transform Infrared Spectroscopy (FT-IR)
2.7. Water Content
2.8. Water Absorption
2.9. Erosion
2.10. Water Vapor Transmission Rate (WVTR)
2.11. Mechanical Properties
2.12. Infiltration Bacterial Test
2.13. Antioxidant Activity
2.14. NHF Cell Viability
2.15. NHF Cell Proliferation
2.16. In Vitro Scratch Assay
2.17. Statistical Analysis
3. Results and Discussion
3.1. The Optimization of the Hydrogel Patches
3.2. Embedding of D. bulbifera Extract to Optimized Film
3.3. FT-IR Spectra
3.4. Water Content
3.5. Water Absorption
3.6. WVTR
3.7. Mechanical Properties
3.8. Infiltration Bacterial Test
3.9. Antioxidant Activity
3.10. NHF Cell Viability
3.11. NHF Cell Proliferation
3.12. In Vitro Scratch Assay
4. Conclusions
Supplementary Materials
Author Contributions
Funding
Institutional Review Board Statement
Informed Consent Statement
Data Availability Statement
Acknowledgments
Conflicts of Interest
References
- Tavakoli, S.; Klar, A.S. Advanced hydrogels as wound dressings. Biomolecules 2020, 10, 1169. [Google Scholar] [CrossRef] [PubMed]
- Yuan, J.; Zhang, D.; He, X.; Ni, Y.; Che, L.; Wu, J.; Wu, B.; Wang, Y.; Wang, S.; Sha, D.; et al. Cationic peptide-based salt-responsive antibacterial hydrogel dressings for wound healing. Int. J. Biol. Macromol. 2021, 190, 754–762. [Google Scholar] [CrossRef] [PubMed]
- Wang, F.; Wang, S.; Nan, L.; Lu, J.; Zhu, Z.; Yang, J.; Zhang, D.; Liu, J.; Zhao, X.; Wu, D. Conductive adhesive and antibacterial zwitterionic hydrogel dressing for therapy of full-thickness skin wounds. Front. Bioeng. Biotechnol. 2022, 10, 833887. [Google Scholar] [CrossRef]
- Suriyaamporn, P.; Rangsimawong, W.; Opanasopit, P.; Ngawhirunpat, T. Development and characterization of Gantrez® S-97 and hyaluronic acid microneedles for transdermal fluorescein sodium delivery. Key Eng. Mater. 2020, 859, 125–131. [Google Scholar] [CrossRef]
- Donnelly, R.F.; McCrudden, M.T.C.; Alkilani, A.Z.; Larrañeta, E.; McAlister, E.; Courtenay, A.J.; Kearney, M.C.; Raj Singh, T.R.; McCarthy, H.O.; Kett, V.L.; et al. Hydrogel-forming microneedles prepared from "super swelling" polymers combined with lyophilised wafers for transdermal drug delivery. PLoS ONE 2014, 9, e111547. [Google Scholar] [CrossRef] [PubMed]
- Suriyaamporn, P.; Opanasopit, P.; Ngawhirunpat, T.; Rangsimawong, W. Computer-aided rational design for optimally Gantrez® S-97 and hyaluronic acid-based dissolving microneedles as a potential ocular delivery system. J. Drug Deliv. Sci. Technol. 2021, 61, 102319. [Google Scholar] [CrossRef]
- Myat, Y.Y.; Aung, N.N.; Ngawhirunpat, T.; Rojanarata, T.; Opanasopit, P.; Patrojanasophon, P. Fabrication and evaluation of thermally crosslinked Gantrez S-97 microneedle arrays. Key Eng. Mater. 2020, 859, 39–44. [Google Scholar] [CrossRef]
- Nishinari, K.; Takemasa, M.; Zhang, H.; Takahashi, R. 2.19—Storage plant Polysaccharides: Xyloglucans, Galactomannans, Glucomannans. In Comprehensive Glycoscience; Kamerling, H., Ed.; Elsevier: Amsterdam, The Netherlands, 2007; pp. 613–652. [Google Scholar] [CrossRef]
- Mabasa Bergström, E.; Salmén, L.; Kochumalayil, J.; Berglund, L. Plasticized xyloglucan for improved toughness—Thermal and mechanical behaviour. Carbohydr. Polym. 2012, 87, 2532–2537. [Google Scholar] [CrossRef]
- Joseph, J.; Kanchalochana, S.N.; Rajalakshmi, G.; Hari, V.; Durai, R.D. Tamarind seed polysaccharide: A promising natural excipient for pharmaceuticals. Int. J. Green Pharm. 2012, 6, 270–278. [Google Scholar]
- Dey, S.; Nandy, B.C.; De, J.N.; Hasnain, M.S.; Nayak, A.K. Chapter 12—Tamarind gum in drug delivery applications. In Natural Polysaccharides in Drug Delivery and Biomedical Applications; Hasnain, M.S., Nayak, A.K., Eds.; Academic Press: Cambridge, MA, USA, 2019; pp. 285–306. [Google Scholar] [CrossRef]
- Nayak, A.K.; Pal, D. Tamarind seed polysaccharide: An emerging excipient for pharmaceutical use. Indian J. Pharm. Educ. Res. 2017, 51, s136–s146. [Google Scholar] [CrossRef] [Green Version]
- Nie, W.; Deters, A.M. Tamarind seed xyloglucans promote proliferation and migration of human skin cells through internalization via stimulation of proliferative signal transduction pathways. Dermatol. Res. Pract. 2013, 2013, 359756. [Google Scholar] [CrossRef] [PubMed] [Green Version]
- Burgalassi, S.; Raimondi, L.; Pirisino, R.; Banchelli, G.; Boldrini, E.; Saettone, M.F. Effect of xyloglucan (tamarind seed polysaccharide) on conjunctival cell adhesion to laminin and on corneal epithelium wound healing. Eur. J. Ophthalmol. 2000, 10, 71–76. [Google Scholar] [CrossRef] [PubMed]
- Mohamad, M.Y.; Akram, H.B.; Bero, D.N.; Rahman, M.T. Tamarind seed extract enhances epidermal wound healing. Int. J. Biol. 2012, 4, 81–88. [Google Scholar] [CrossRef]
- Picone, P.; Sabatino, M.A.; Ajovalasit, A.; Giacomazza, D.; Dispenza, C.; Di Carlo, M. Biocompatibility, hemocompatibility and antimicrobial properties of xyloglucan-based hydrogel film for wound healing application. Int. J. Biol. Macromol. 2019, 121, 784–795. [Google Scholar] [CrossRef]
- Hirose, K.; Sasatsu, M.; Toraishi, T.; Onishi, H. Novel xyloglucan sheet for the treatment of deep wounds: Preparation, physicochemical characteristics, and in vivo healing effects. Biol. Pharm. Bull. 2019, 42, 1409–1414. [Google Scholar] [CrossRef] [Green Version]
- Arruda, I.R.S.; Souza, M.P.; Soares, P.A.G.; Albuquerque, P.B.S.; Silva, T.D.; Medeiros, P.L.; Silva, M.V.; Correia, M.T.S.; Vicente, A.A.; Carneiro-da-Cunha, M.G. Xyloglucan and Concanavalin A based dressings in the topical treatment of mice wound healing process. Carbohydr. Polym. Technol. Appl. 2021, 2, 100136. [Google Scholar] [CrossRef]
- Ajovalasit, A.; Sabatino, M.A.; Todaro, S.; Alessi, S.; Giacomazza, D.; Picone, P.; Di Carlo, M.; Dispenza, C. Xyloglucan-based hydrogel films for wound dressing: Structure-property relationships. Carbohydr. Polym. 2018, 179, 262–272. [Google Scholar] [CrossRef] [PubMed]
- Ajovalasit, A.; Caccami, M.C.; Amendola, S.; Sabatino, M.A.; Alotta, G.; Zingales, M.; Giacomazza, D.; Occhiuzzi, C.; Marrocco, G.; Dispenza, C. Development and characterization of xyloglucan-poly (vinyl alcohol) hydrogel membrane for wireless smart wound dressings. Eur. Polym. J. 2018, 106, 214–222. [Google Scholar] [CrossRef]
- Kundu, B.B.; Vanni, K.; Farheen, A.; Jha, P.; Pandey, D.K.; Kumar, V. Dioscorea bulbifera L. (Dioscoreaceae): A review of its ethnobotany, pharmacology and conservation needs. S. Afr. J. Bot. 2021, 140, 365–374. [Google Scholar] [CrossRef]
- Ghosh, S.; Parihar, V.S.; More, P.; Dhavale, D.D.; Chopade, B.A. Phytochemistry and therapeutic potential of medicinal plant: Dioscorea bulbifera. Med. Chem. 2015, 5, 160–172. [Google Scholar] [CrossRef]
- Guan, X.R.; Zhu, L.; Xiao, Z.G.; Zhang, Y.L.; Chen, H.B.; Yi, T. Bioactivity, toxicity and detoxification assessment of Dioscorea bulbifera L.: A comprehensive review. Phytochem. Rev. 2017, 16, 573–601. [Google Scholar] [CrossRef]
- Panduraju, T.; Bitra, V.R.; Vemula, S.K.; Reddy, P.R.V. Wound healing activity of Dioscorea bulbifera Linn. J. Pharm. Res. 2010, 3, 3138–3139. [Google Scholar]
- Chaniad, P.; Tewtrakul, S.; Sudsai, T.; Langyanai, S.; Kaewdana, K. Anti-inflammatory, wound healing and antioxidant potential of compounds from Dioscorea bulbifera L. bulbils. PLoS ONE 2020, 15, e0243632. [Google Scholar] [CrossRef]
- Eakwaropas, P.; Ngawhirunpat, T.; Patrojanasophon, P.; Charoensuksai, P.; Nuntharatanapon, N.; Opanasopit, P. Fibroblast viability, proliferation and migration of Dioscorea bulbifera L. gel. In Proceedings of the 6th Current Drug Development (CDD) International Conference 2020, Songkhla, Thailand, 10–12 September 2020. [Google Scholar]
- Keskin, M.; Keskin, Ş.; Kolaylı, S. Chapter 17—Health-promoting benefits of honey. In Preparation of Phytopharmaceuticals for the Management of Disorders; Egbuna, C., Mishra, A.P., Goyal, M.R., Eds.; Academic Press: Cambridge, MA, USA, 2021; pp. 303–306. [Google Scholar] [CrossRef]
- Bastos, D.H.M.; Sampaio, G.R. Chapter 47—Antioxidant Capacity of Honey: Potential Health Benefit. In Bioactive Food as Dietary Interventions for Diabetes; Watson, R.R., Preedy, V.R., Eds.; Academic Press: Cambridge, MA, USA, 2013; pp. 609–619. [Google Scholar] [CrossRef]
- Ebadi, P.; Fazeli, M. Evaluation of the potential in vitro effects of propolis and honey on wound healing in human dermal fibroblast cells. S. Afr. J. Bot. 2021, 137, 414–422. [Google Scholar] [CrossRef]
- Nordin, A.; Omar, N.; Sainik, N.Q.A.V.; Chowdhury, S.R.; Omar, E.; Bin Saim, A.; Bt Hj Idrus, R. Low dose stingless bee honey increases viability of human dermal fibroblasts that could potentially promote wound healing. Wound Med. 2018, 23, 22–27. [Google Scholar] [CrossRef]
- Abou Zekry, S.S.; Abdellatif, A.; Azzazy, H.M.E. Fabrication of pomegranate/honey nanofibers for use as antibacterial wound dressings. Wound Med. 2020, 28, 100181. [Google Scholar] [CrossRef]
- Ullah, A.; Ullah, S.; Khan, M.Q.; Hashmi, M.; Nam, P.D.; Kato, Y.; Tamada, Y.; Kim, I.S. Manuka honey incorporated cellulose acetate nanofibrous mats: Fabrication and in vitro evaluation as a potential wound dressing. Int. J. Biol. Macromol. 2020, 155, 479–489. [Google Scholar] [CrossRef]
- Tang, Y.; Lan, X.; Liang, C.; Zhong, Z.; Xie, R.; Zhou, Y.; Miao, X.; Wang, H.; Wang, W. Honey loaded alginate/PVA nanofibrous membrane as potential bioactive wound dressing. Carbohydr. Polym. 2019, 219, 113–120. [Google Scholar] [CrossRef] [PubMed]
- Rezvanian, M.; Ahmad, N.; Mohd Amin, M.C.I.; Ng, S.F. Optimization, characterization, and in vitro assessment of alginate-pectin ionic cross-linked hydrogel film for wound dressing applications. Int. J. Biol. Macromol. 2017, 97, 131–140. [Google Scholar] [CrossRef] [PubMed]
- Grada, A.; Otero-Vinas, M.; Prieto-Castrillo, F.; Obagi, Z.; Falanga, V. Research techniques made simple: Analysis of collective cell migration using the wound healing assay. J. Invest. Dermatol. 2017, 137, e11–e16. [Google Scholar] [CrossRef] [Green Version]
- Abdelrahman, T.; Newton, H. Wound dressings: Principles and practice. Surgery 2011, 29, 491–495. [Google Scholar] [CrossRef]
- Comino-Sanz, I.M.; López-Franco, M.D.; Castro, B.; Pancorbo-Hidalgo, P.L. The role of antioxidants on wound healing: A review of the current evidence. J. Clin. Med. 2021, 10, 3558. [Google Scholar] [CrossRef] [PubMed]
- Fitzmaurice, S.D.; Sivamani, R.K.; Isseroff, R.R. Antioxidant therapies for wound healing: A clinical guide to currently commercially available products. Ski. Pharmacol. Physiol. 2011, 24, 113–126. [Google Scholar] [CrossRef] [PubMed]
- Comino-Sanz, I.M.; López-Franco, M.D.; Castro, B.; Pancorbo-Hidalgo, P.L. Antioxidant dressing therapy versus standard wound care in chronic wounds (the REOX study): Study protocol for a randomized controlled trial. Trials 2020, 21, 505. [Google Scholar] [CrossRef] [PubMed]
- Saqib, A.A.N.; Whitney, P.J. Differential behaviour of the dinitrosalicylic acid (DNS) reagent towards mono- and di-saccharide sugars. Biomass Bioenergy 2011, 35, 4748–4750. [Google Scholar] [CrossRef]




) agar without bacteria, (
) agar with bacteria, (
) Gan/XG hydrogel patch, (
) honey-loaded Gan/XG hydrogel patch, and (
) D. bulbifera extract/honey-loaded Gan/XG hydrogel patch.
) agar without bacteria, (
) agar with bacteria, (
) Gan/XG hydrogel patch, (
) honey-loaded Gan/XG hydrogel patch, and (
) D. bulbifera extract/honey-loaded Gan/XG hydrogel patch.
) Gan/XG hydrogel patches, (
) honey-loaded Gan/XG hydrogel patches, and (
) D. bulbifera extract/honey-loaded Gan/XG hydrogel patches at 0.5, 1, 2, 4, and 6 h. * p-value < 0.05 of honey-loaded Gan/XG compared with Gan/XG at the same concentration.
) Gan/XG hydrogel patches, (
) honey-loaded Gan/XG hydrogel patches, and (
) D. bulbifera extract/honey-loaded Gan/XG hydrogel patches at 0.5, 1, 2, 4, and 6 h. * p-value < 0.05 of honey-loaded Gan/XG compared with Gan/XG at the same concentration.
) Gan/XG hydrogel patches, (
) honey-loaded Gan/XG hydrogel patches, and (
) D. bulbifera extract/honey-loaded Gan/XG hydrogel patches. * p-value < 0.05 compared to untreated cells (control group).
) Gan/XG hydrogel patches, (
) honey-loaded Gan/XG hydrogel patches, and (
) D. bulbifera extract/honey-loaded Gan/XG hydrogel patches. * p-value < 0.05 compared to untreated cells (control group).
) Gan/XG hydrogel patches, (
) honey-loaded Gan/XG hydrogel patches, and (
) D. bulbifera extract/honey-loaded Gan/XG hydrogel patches. * p-value < 0.05 compared to untreated cells (control group).
) Gan/XG hydrogel patches, (
) honey-loaded Gan/XG hydrogel patches, and (
) D. bulbifera extract/honey-loaded Gan/XG hydrogel patches. * p-value < 0.05 compared to untreated cells (control group).
) control (untreated cells) and treated cells with extraction medium of hydrogel patches: (
) Gan/XG, (
) honey-loaded Gan/XG, and (
) D. bulbifera extract/honey-loaded Gan/XG. p-value < 0.05 compared to untreated cells (*) and D. bulbifera extract/honey-loaded Gan/XG (**) at the same incubation time.
) control (untreated cells) and treated cells with extraction medium of hydrogel patches: (
) Gan/XG, (
) honey-loaded Gan/XG, and (
) D. bulbifera extract/honey-loaded Gan/XG. p-value < 0.05 compared to untreated cells (*) and D. bulbifera extract/honey-loaded Gan/XG (**) at the same incubation time.
| Factors | Responses | ||||||
|---|---|---|---|---|---|---|---|
| A: Gan (%) | B: XG (%) | Y1: Water Absorption (%) | Y2: Tensile Strength (MPa) | Y3: Young’s Modulus (MPa) | Y4: Elongation (%) | Y5: Erosion (%) | Y6: Water Content (%) |
| 18.62 | 0.175 | 505.35 | 0.184 | 0.067 | 284.45 | 5.44 | 45.27 |
| 18.00 | 0.100 | 912.42 | 0.071 | 0.015 | 360.20 | 26.29 | 44.01 |
| 14.38 | 0.175 | 265.64 | 0.134 | 0.108 | 230.60 | 16.67 | 49.22 |
| 16.50 | 0.281 | 247.17 | 0.405 | 0.242 | 210.75 | 0.00 | 46.75 |
| 15.00 | 0.250 | 130.93 | 0.241 | 0.176 | 194.10 | 6.90 | 45.52 |
| 15.00 | 0.100 | 623.50 | 0.051 | 0.030 | 370.15 | 24.14 | 50.22 |
| 16.50 | 0.175 | 532.74 | 0.290 | 0.101 | 273.85 | 18.33 | 50.74 |
| 16.50 | 0.175 | 411.39 | 0.306 | 0.125 | 308.15 | 25.00 | 50.91 |
| 16.50 | 0.175 | 430.18 | 0.332 | 0.068 | 301.65 | 21.21 | 50.75 |
| 18.00 | 0.250 | 269.17 | 0.302 | 0.165 | 246.28 | 0.00 | 48.18 |
| 16.50 | 0.175 | 405.25 | 0.267 | 0.099 | 299.63 | 24.24 | 50.81 |
| 16.50 | 0.069 | 798.35 | 0.112 | 0.028 | 420.15 | 24.24 | 46.75 |
| 16.50 | 0.175 | 439.03 | 0.327 | 0.084 | 255.45 | 15.42 | 50.23 |
| Coefficient | Y1 | Y2 | Y3 | Y4 | Y5 | Y6 |
|---|---|---|---|---|---|---|
| b0 | 443.72 | 0.3043 | 0.0954 | 287.75 | 20.84 | 50.69 |
| b1 | 95.77 | 0.0189 | −0.0106 | 14.80 | −2.58 | −1.14 |
| b2 | −239.41 | 0.1044 | 0.0749 | −73.26 | −9.73 | −0.0660 |
| b12 | −37.67 | 0.0101 | 0.0009 | 15.53 | −2.26 | 2.22 |
| b11 | −21.64 | −0.0833 | −0.0077 | −13.56 | −4.21 | −1.72 |
| b22 | 46.99 | −0.0335 | 0.0160 | 15.40 | −3.67 | −1.97 |
| p-value | 0.0002 | 0.0001 | 0.0002 | 0.0001 | 0.0018 | <0.0001 |
| R2 | 0.9502 | 0.9565 | 0.9535 | 0.9568 | 0.9062 | 0.9887 |
| Hydrogel Patches | Water Content (%) | Water Absorption (%) | WVTR (g/m2/day) |
|---|---|---|---|
| Gan/XG | 89.24 ± 0.71 | 300.41 ± 13.45 | N/A |
| honey-loaded Gan/XG | 48.64 ± 0.60 | 466.89 ± 8.48 * | 516.51 ± 12.86 |
| D. bulbifera extract/honey-loaded Gan/XG | 45.35 ± 1.18 | 650.19 ± 21.30 *,** | 576.62 ± 32.52 |
| Hydrogel Patches | Young’s Modulus (MPa) | Tensile Strength (MPa) | Elongation (%) |
|---|---|---|---|
| Gan/XG | 0.271 ± 0.010 | 0.146 ± 0.009 | 59.47 ± 4.14 |
| honey-loaded Gan/XG | 0.349 ± 0.022 * | 0.229 ± 0.018 * | 131.01 ± 7.55 * |
| D. bulbifera extract/honey-loaded Gan/XG | 0.253 ± 0.015 ** | 0.243 ± 0.027 * | 191.18 ± 14.88 *,** |
| Gan/XG | Honey-Loaded Gan/XG | D. bulbifera Extract/Honey-Loaded Gan/XG | |
|---|---|---|---|
| S. aureus | ![]() | ![]() | ![]() |
| E. coli | ![]() | ![]() | ![]() |
| Samples | Incubation Time (h) | |||
|---|---|---|---|---|
| 1 h | 2 h | 4 h | 6 h | |
| Gan/XG | ![]() | ![]() | ![]() | ![]() |
| Honey-loaded Gan/XG | ![]() | ![]() | ![]() | ![]() |
| D. bulbifera extract/honey-loaded Gan/XG | ![]() | ![]() | ![]() | ![]() |
| Samples | Migration Test | |||
|---|---|---|---|---|
| 0 h | 24 h | 48 h | 72 h | |
| Control | ![]() | ![]() | ![]() | ![]() |
| D. bulbifera extract/honey-loaded Gan/XG | ![]() | ![]() | ![]() | ![]() |
| Honey-loaded Gan/XG | ![]() | ![]() | ![]() | ![]() |
| Gan/XG | ![]() | ![]() | ![]() | ![]() |
Publisher’s Note: MDPI stays neutral with regard to jurisdictional claims in published maps and institutional affiliations. |
© 2022 by the authors. Licensee MDPI, Basel, Switzerland. This article is an open access article distributed under the terms and conditions of the Creative Commons Attribution (CC BY) license (https://creativecommons.org/licenses/by/4.0/).
Share and Cite
Eakwaropas, P.; Ngawhirunpat, T.; Rojanarata, T.; Patrojanasophon, P.; Opanasopit, P.; Nuntharatanapong, N. Formulation and Optimal Design of Dioscorea bulbifera and Honey-Loaded Gantrez®/Xyloglucan Hydrogel as Wound Healing Patches. Pharmaceutics 2022, 14, 1302. https://doi.org/10.3390/pharmaceutics14061302
Eakwaropas P, Ngawhirunpat T, Rojanarata T, Patrojanasophon P, Opanasopit P, Nuntharatanapong N. Formulation and Optimal Design of Dioscorea bulbifera and Honey-Loaded Gantrez®/Xyloglucan Hydrogel as Wound Healing Patches. Pharmaceutics. 2022; 14(6):1302. https://doi.org/10.3390/pharmaceutics14061302
Chicago/Turabian StyleEakwaropas, Pattaranut, Tanasait Ngawhirunpat, Theerasak Rojanarata, Prasopchai Patrojanasophon, Praneet Opanasopit, and Nopparat Nuntharatanapong. 2022. "Formulation and Optimal Design of Dioscorea bulbifera and Honey-Loaded Gantrez®/Xyloglucan Hydrogel as Wound Healing Patches" Pharmaceutics 14, no. 6: 1302. https://doi.org/10.3390/pharmaceutics14061302
APA StyleEakwaropas, P., Ngawhirunpat, T., Rojanarata, T., Patrojanasophon, P., Opanasopit, P., & Nuntharatanapong, N. (2022). Formulation and Optimal Design of Dioscorea bulbifera and Honey-Loaded Gantrez®/Xyloglucan Hydrogel as Wound Healing Patches. Pharmaceutics, 14(6), 1302. https://doi.org/10.3390/pharmaceutics14061302